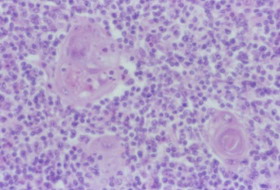

目的与要求
1.掌握淋巴结和脾的组织结构,了解胸腺和腔上囊的结构特点。
2.掌握甲状腺、甲状旁腺、肾上腺和脑垂体的微细结构。
免疫器官实验内容
一、显微镜下观察
1. 胸腺
2. 淋巴结
3. 脾
1. 胸腺


胸腺小叶

胸腺皮质 胸腺髓质
2. 淋巴结


淋巴结的低倍 淋巴结皮质


副皮质区 皮质淋巴窦

淋巴结髓质
3. 脾


脾白髓 脾红髓

猪脾
二、示教
1. 腔上囊
2. 猪淋巴结
1. 腔上囊


小鸭腔上囊横切 腔上囊黏膜皱襞

腔上囊小结
2. 猪淋巴结

猪的淋巴结结构
三、绘图作业
1.绘制淋巴结局部低倍镜图
标注:被膜、小梁、门部、淋巴小结、副皮质区、皮质淋巴窦、髓索、髓质淋巴窦

淋巴结皮质和髓质
2.绘制脾局部低倍镜图
标注:被膜、小梁、脾小结、中央动脉、动脉周围淋巴组织鞘、脾索、脾窦

脾
内分泌腺实验内容
一、显微镜下观察
1. 甲状腺
2. 甲状旁腺
3. 肾上腺
4. 脑垂体
1. 甲状腺


甲状腺滤泡
2. 甲状旁腺


甲状腺与甲状旁腺 甲状旁腺的组织结构
3. 肾上腺



4. 脑垂体


猪的脑垂体 垂体主部


垂体远侧部 垂体茎

神经垂体
二、示教
甲状腺滤泡旁细胞

三、绘图作业
1.绘制甲状腺滤泡高倍镜图
标注:滤泡上皮细胞、滤泡旁细胞、胶状物质

甲状腺滤泡
2.绘制脑垂体分部图
标注:远侧部、中间部神经部、漏斗部、结节部、垂体裂、垂体腔

猪的脑垂体